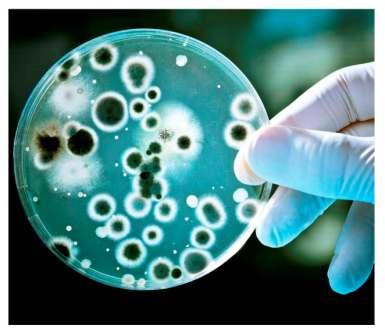

Четвер, 28 березня 2013 13:38
Біопрепарати в боротьбі зі шкідниками
Ганна ТКАЛЕНКО, канд. с.-г. наук
Інститут захисту рослин НААН
Одним з основних шляхів одержання екологічно безпечної продукції рослинництва є застосування біологічного методу захисту рослин як основного стратегічного еколого-біологічного заходу контролю шкідливих організмів у посівах сільськогосподарських культур та екологічного землеробства.
У захисті рослин від шкідників і хвороб широко застосовують мікробні препарати на основі різних видів мікроорганізмів і метаболітів, які вони синтезують. Біопрепарати застосовуються як інсектициди, фунгіциди і протруювачі для захисту рослин від шкідників і хвороб. Слід зазначити, що біологічний метод ефективний за постійного поповненняагроценозів біологічними агентами. Особливого поширення біологічний метод боротьби в Україні набув у другій половині минулого століття.
 В Україні до «Переліку пестицидів та агрохімікатів» (2012 р.) включено 60 біологічних засобів захисту (див. табл.). Широко застосовуються в агроценозах сільгоспкультур для захисту від шкідників біологічні препарати на основі Bacillus thuringiensis.
В Україні до «Переліку пестицидів та агрохімікатів» (2012 р.) включено 60 біологічних засобів захисту (див. табл.). Широко застосовуються в агроценозах сільгоспкультур для захисту від шкідників біологічні препарати на основі Bacillus thuringiensis.
Біопрепарат Бітоксибацилін виготовляється на основі Bacillus thuringiensis var. thuringiensis, який, окрім ендотоксину, містить термостабільний екзотоксин. Завдяки тому, що в препараті містяться токсини двох типів, він має широкий спектр дії проти лускокрилих, сисних і твердокрилих шкідників. Ефективний проти гусениць 1-2 віків капустяного та ріпакового біланів, капустяної молі, вогнівок на капусті та інших овочевих культурах. Два обприскування через 6-7 днів проти кожного покоління шкідників забезпечує ефективність на рівні 90-95%. На огірках закритого ґрунту - проти павутинного кліща і баштанної попелиці в період вегетації з інтервалом 15-17 днів, знижує чисельність шкідників на 86,5-88%. Характерною особливістю застосування біологічного препарату Бітоксибациліну є порушення метоморфозу у комах, що проявляється в утворенні великої кількості химерних особин шкідників, зниженні життєздатності та плодючості комах.
Бактеріальний біопрепарат Лепідоцид розроблений на основі Bacillus thuringiensis var. kurstaki, 3-й серотип ефективний проти гусениць 1-2-го віку лучного метелика, біланів, капустяної молі, вогнівок, капустяної і сірої зернової совки. За застосування біопрепарату проти лускокрилих шкідників чисельність їх знижується на 78,5-84,8%. На яблуні 1-2 обприскування у період вегетації через 6-7 днів проти кожного покоління гусениць 1-3-го віку яблуневої молі, п’ядунів, листокруток весняної групи, пильщиків суттєво знижує пошкодженість цими фітофагами. Дворазове обприскування Лепідоцидом знижує чисельність капустяної совки на 70-80%, капустяного і ріпакового біланів, а також молей до 90%. Ефективний біопрепарат Лепідоцид і на картоплі проти картопляної молі (4 л/га) за обприскування посівів і обробки бульб перед закладанням усховища.
В останні роки широко застосовується розроблений біологічний препарат на основі аверсектинів Актофіт проти колорадського жука на картоплі та павутинного кліща - на огірках і трояндах закритого ґрунту. Слід зазначити, що тільки за чіткого дотримання дозволених норм і кратності обробок забезпечується тривале збереження ефективності цього препарату. При застосуванні робочої концентрації Актофіта 0,2% загибель звичайного і червоного павутинних кліщів досягає 80-90%, подавляється розвиток близько 40% яєць, на 5-ту добу - формування яєць не відбувається, вони висихають, зморщуються. Повторна обробка препаратом після відродження виживших особин забезпечує високий захисний ефект.
Проти колорадського жука на картоплі біопрепарат Актофіт необхідно застосовувати проти личинок молодших віків (1-3) і за температури не нижче +20С0. За недотримання цих вимог ефективність препарату значно знижується.
Для боротьби з мишовидними гризунами - Rodentia- рекомендований бактеріальний препарат Бактороденцид, створений на основі бактерій Ісаченка - Salmonellaenteritidis. Найбільш чутливі до бактороденциду миша хатня - MusmusculusL., лісова - ApodemussilvaticusL., польова - MicrotusagrariusL.
 Бактороденцид можна розсівати по полю з літака, сівалки, машинами для внесення мінеральних добрив. Висока чисельність мишовидних гризунів у місцях їх осінньо-зимового перебування створює сприйнятливі умови для розвитку захворювання, викликаного застосуванням Бактороденциду. Для летального кінця миші або полівки досить з’їсти два зернятка препарату зернового. Зовсім не обов'язково проводити повну обробку, достатньо організувати довгострокові осередки зараження у визначених місцях. Наприклад, у лісосмугах їх створюють під оберемками соломи, сіна, розкладаючи по 30 г Бактороденциду через кожні 25-30 м.
Бактороденцид можна розсівати по полю з літака, сівалки, машинами для внесення мінеральних добрив. Висока чисельність мишовидних гризунів у місцях їх осінньо-зимового перебування створює сприйнятливі умови для розвитку захворювання, викликаного застосуванням Бактороденциду. Для летального кінця миші або полівки досить з’їсти два зернятка препарату зернового. Зовсім не обов'язково проводити повну обробку, достатньо організувати довгострокові осередки зараження у визначених місцях. Наприклад, у лісосмугах їх створюють під оберемками соломи, сіна, розкладаючи по 30 г Бактороденциду через кожні 25-30 м.
У скирдах соломи кращі результати одержують при розміщенні препарату (по 30 г) в дератизаційних ящиках, встановлених у нішах через кожні 5 м, у 2 ряди в шаховому порядку. На полях багаторічних трав препарат викладають по периметру масиву в дві лінії (зовнішня у 30 м від краю поля, внутрішня - на віддалі 30 м від зовнішньої). Застосування Бактороденциду дозволяє досягнути високої ефективності: в лісосмугах - до 85 %, в скирдах - до 75 %, на полях багаторічних трав - до 80%, що дає економію значних матеріальних і фінансових витрат і забезпечує цілеспрямоване і повне використання препарату. Однак завдяки сприйнятливим погодним умовам, монокультурному вирощуванню культур різко зростає чисельність гризунів, а відповідно і потреба в біологічному препараті.
В останні роки вченими виділено ряд бактерій і грибів, що мають антагоністичні властивості до патогенів рослин. Найбільше поширені і застосовуються бактеріальні препарати на основі Bacillus subtilis, Pseudomonas aurefaciens, P. fluorescens.На їх основі зареєстровано 6 біопрепаратів: Бактофіт, Бізар, Планриз, Псевдобактерин, ФітоДоктор, які виявляють антагоністичну активність до широкого спектра фітопатогенів родів Erwinia, Fusarium, Rhizoctonia, Botritis,Pythium, Verticillium,Sclerotinia, Phytophthora,Ascohyta.
Протягом багатьох років для захисту рослин застосовується бактеріальний препарат Планриз на основі псевдомонад, спектр дії якого досить широкий: на зернових проти кореневих гнилей, помідорах і огірках проти бактеріозу, фузаріозу, вертицильозу, риктоніозу, кореневих гнилей, на капусті проти чорної ніжки, бактеріозів; в саду проти парші. Бактерії добре засвоюють різні органічні субстрати, швидше інших мікроорганізмів колонізують всю кореневу систему, продукують антибіотики і сидерофори, пригнічуючи розвиток фітопатогенних грибів.
На основі бактерій Pseudomonas aurefaciens створено біопрепарати Агат, Бізар, Псевдобактерин, застосування яких в агроекосистемах знижує ураженість зернових, овочевих, цукрових буряків збудниками грибних і бактеріальних хвороб і підвищує у середньому врожайність картоплі на 15,5-45 ц/га, цукрових буряках - 23-35 ц/га, зернових - 1,5-5,5 ц/га.
Розроблений бактеріальний інсекто-фунгіцидний препарат Гаупсин, який є рідиною, що містить життєздатні клітини бактерій Pseudomonas aureofaciens і залишки компонентів живильного середовища, ефективний проти шкідників та хвороб зерняткових плодових культур (гусениць яблуневої плодожерки, парші, плодових гнилей), а також гнилей овочевих культур закритого ґрунту. Застосування Гаупсину знижує ураженість плодів яблуні яблуневою плодожеркою за двох обробок проти першого покоління і однієї проти другого на 85-92% і грибними захворюваннями на 94-96%, а по рентабельності не поступається хімічним препаратам.
Розроблений бактеріальний інсекто-фунгіцидний препарат Гаупсин, який є рідиною, що містить життєздатні клітини бактерій Pseudomonas aureofaciens і залишки компонентів живильного середовища, ефективний проти шкідників та хвороб зерняткових плодових культур (гусениць яблуневої плодожерки, парші, плодових гнилей), а також гнилей овочевих культур закритого ґрунту. Застосування Гаупсину знижує ураженість плодів яблуні яблуневою плодожеркою за двох обробок проти першого покоління і однієї проти другого на 85-92% і грибними захворюваннями на 94-96%, а по рентабельності не поступається хімічним препаратам.
Особливо широко вивчені гриби з роду Trichoderma, які мають широке практичне застосування. Нині на основі досить поширеного гриба TrichodermalignorumHarz. іTrichodermaviridae створено грибний біологічний препарат Триходермін, який є антагоністом багатьох фітопатогенних грибів, пов’язаних у своєму розвитку із ґрунтом. Препарат характеризується високою активністю стосовно багатьох збудників хвороб рослин із родів Alternaria, Botrytis, Colletotrichum, Fusarium, Phoma, Pythium, Rhizoctonia, Sclerotinia, Verticilliun. Гриб триходерма продукує мікотоксин і антибіотики, які мають антибактеріальну дію. Біопрепарат забезпечує високу ефективність проти кореневих гнилей, білої гнилі, фузаріозного та вертицильозного в’янення овочевих культур відкритого і закритого ґрунту.
На основі проведених досліджень встановлено, що для захисту рослин від хвороб потрібне 3-4-разове застосування біопрепарату Триходермін: під час посіву та в період вегетації. Застосування цього препарату в суміші з бактеріальним препаратом Планриз в овочевих агроценозах суттєво знижує ураженість рослин хворобами, збільшує урожайність огірків і томатів до 6,5-8 кг/1м2, сприяє збільшенню виходу стандартної продукції.
На основі афілофорального гриба Fomes fomentarius створено препарат Мікосан, який за обробки насіння цукрових буряків, пшениці, кукурудзи, гороху захищає рослини від коренеїду, підвищує їх урожайність.
Проти бактеріальних хвороб томатів і бактеріального раку яблуні розроблений біопрепарат Казумін 2 Л, в. р. (продукт ферментації Streptomyces kasugaensis), який застосовують у період вегетації.
Протягом останніх десятиліть в Україні створено значну кількість (нині 39) біологічних препаратів на основі різних видів бактерій для підвищення урожайності, засвоювання, зв’язування та фіксації атмосферного азоту,мобілізації важкодоступного фосфору з ґрунту, розробниками яких є Інститут сільськогосподарської мікробіології НААН, Інститут мікробіології і вірусології НАНУ, Інститут агроекології і економіки природокористування НААН , БТУ Центр Україна та інші установи. Ці препарати застосовують на овочевих культурах у відкритому і закритому ґрунті, бобових, зернових, цукрових буряках, ріпаку, соняшнику, кукурудзі. За даними науковців (Надкренична, Курдиш, Титова, Алещенкова) застосування біопрепаратів на основі азотофіксуючих і фосфатомобілізуючих бактерій за обробки насіння, позакореневого живлення значно поліпшують ріст і розвиток рослин, сприяють більш ранньому цвітінню та забезпечують прибавку урожаю до 23-33,5%.
Виходячи з цього, є всі підстави вважати, що обсяги застосування біологічних препаратів будуть збільшуватися, а цей напрям у землеробстві через чисельні й різноманітні екологічні проблеми й бажання населення вживати екологічно чисту і повноцінну продукцію буде розвиватися й надалі.
Опубліковано в
Агрономія Сьогодні


